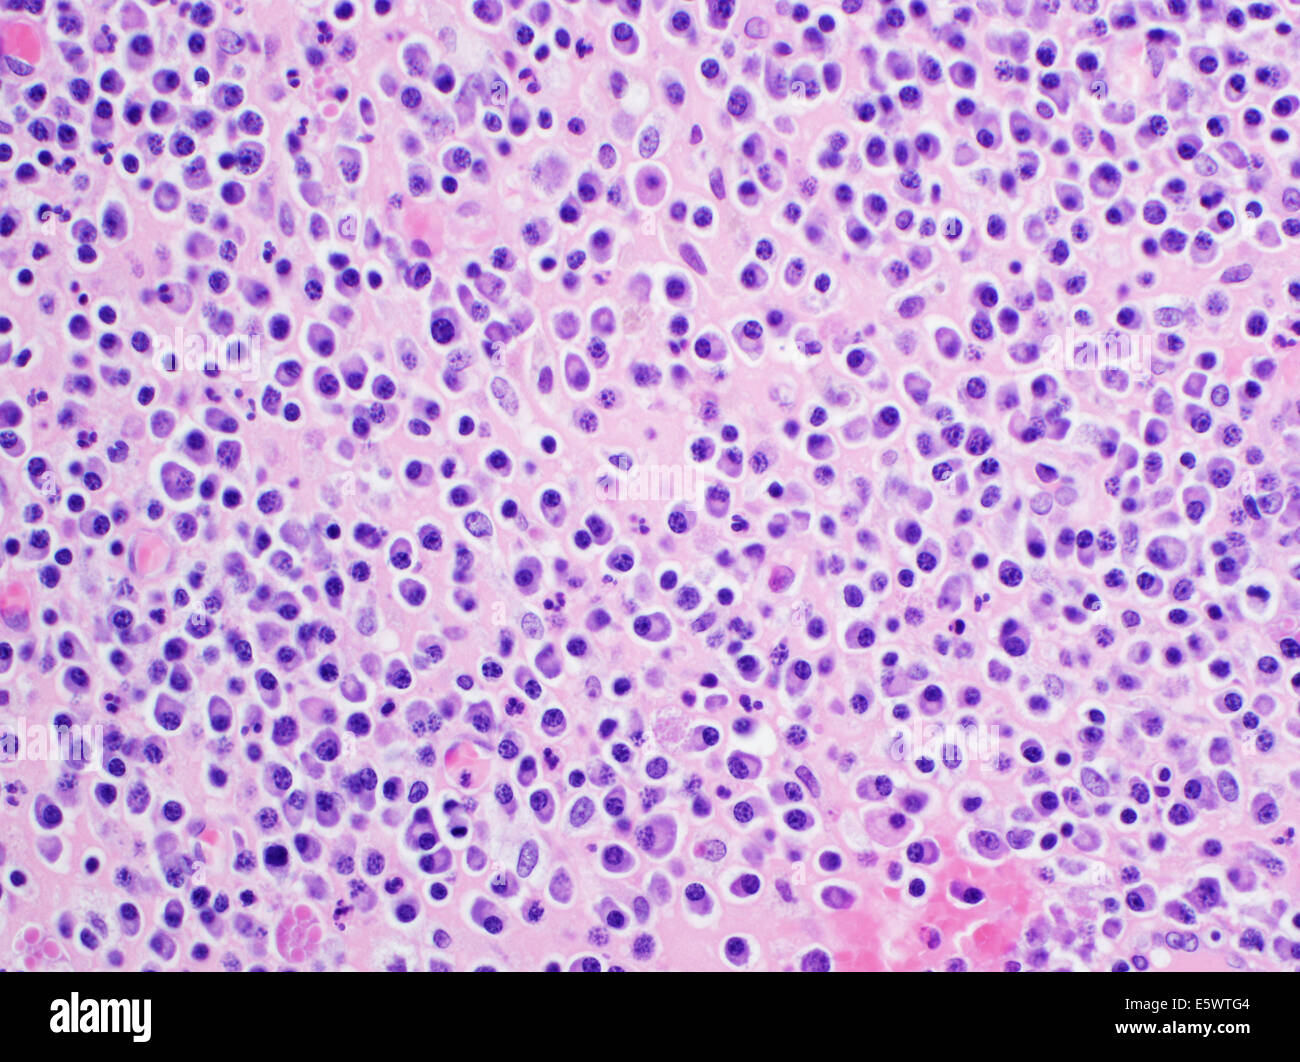
H&E macchia, la microscopia ottica, mieloma multiplo Foto Stock

Microscopio ottico a microscopio ottico Immagini Stock
(5,283)Filtri rapidi:
Microscopio ottico a microscopio ottico Immagini Stock

RF2M640C1–Stelo Zea, stelo di mais, sezione trasversale, micrografia leggera 20X. Stelo della pianta Zea mays, sotto il microscopio luminoso.

RM2BE0HBJ–Micrografia leggera della cellula di coltura tissutale dal cuore di pollo. Ingrandimento 4500x.

RMMBNRWK–Campo scuro micrografia luce di Lactarius rubrilacteus (spurgo) milkcap spore di funghi, area raffigurato è di circa 120 micron ampia

RF2C8BGH9–Vista microscopica di un particolare di pianta di Daphne mezereum. Luce polarizzata, polarizzatori incrociati.

RMTW1M4B–Immagine al microscopio di granuli di polline sulla stame di un giglio fiore (Lilium) a circa 30x di ingrandimento, 25 maggio 2019. ()

RMH4E4N2–Il quarzo-mica-scisto, Loch Linnhe, ghiaiosa, Scotland, Regno Unito. Luce polarizzata microfotografia.

RME8KT0C–Questo Giemsa-colorate microfotografia ottica ha rivelato la presenza di due Trypanosoma brucei parassiti che sono stati trovati nel sangue

RF2Y8MDK6–Solfato di potassio al microscopio, con ingrandimento 80x e luce polarizzata. Il solfato di potassio è un componente dei fertilizzanti

RM2RTNC1G–L'immagine presenta la salsa di soia cristallizzata, fotografata attraverso il microscopio a luce polarizzata con un ingrandimento di 100X.

RF2J1YWCN–sezione trasversale della lingua del gatto sotto il microscopio che mostra papille foliate, papille gustative, submucosa e muscolo - microscopio ottico ingrandimento x100

RF2M451F0–Radice di rafano, sezione trasversale al microscopio ottico. Sezione trasversale attraverso la radice della pianta di Raphanus sativus. Micrografia con ingrandimento 8X.

RMTW1M4N–Close-up immagine al microscopio della struttura interna di una margherita (Gerbera daisy) fiore, 25 maggio 2019. ()

RMKA1M0P–Cinconidina vetrino per microscopio fuso, cinconidina è un alcaloide trovato in China officinalis e Gongronema latifolium, polarizzata incrociata microfotografia.

RME8KT0B–Questo Giemsa-colorate microfotografia ottica ha rivelato la presenza di due Trypanosoma brucei parassiti che sono stati trovati nel sangue

RM2RPEJ1M–L'immagine presenta Simocephalus sp. con le uova, una specie di cladocerano, fotografato attraverso il microscopio a luce polarizzata con un ingrandimento di 100

RFJ1D109–Capsula di spore di Plagiomnium, affine molti a frutto grosso Timo-moss, immagine al microscopio

RF2M4BCFX–Tendine, sezione, micrografia a luce 20X. Pezzo di pecora, colorato con ematossilina ed eosina, al microscopio.

RMBXY610–Luce micrografie di basswood (Tilia americana) steli in sezione trasversale. Un anno attraverso tre anni di esemplari.

RMPC31RP–Micrografia di luce di un piccolo coleottero rove (Staphylinidae) Testa, area raffigurato è di circa 1mm di larghezza

RMTW1MFT–Immagine al microscopio di una superficie in acciaio inossidabile a circa 30x di ingrandimento, 25 maggio 2019. ()

RMKA1M8M–Cinconidina vetrino per microscopio fuso, cinconidina è un alcaloide trovato in China officinalis e Gongronema latifolium, polarizzata incrociata microfotografia.

RM2JKFT9F–Questa immagine mostra il modello di crimpatura (ondulazione) delle fibre di collagene in un legamento collaterale mediale, che è il legamento all'interno del ginocchio. La sezione di legamento è stata ingrandita a 200X usando microscopia a luce polarizzata.

RM2RPEHF5–L'immagine presenta bolle d'aria fotografate attraverso il microscopio in luce polarizzata con un ingrandimento di 100X.

RFRTF5AR–Cristalli di conservante alimentare chiamato acido citrico, microscopio immagine fotografata in croce-luce polarizzata

RF2Y1BJKX–Stelo Willow, sezione trasversale, sotto il microscopio leggero. STEM of Salix, noto anche come Sallows and osiers, micrografo a luce 8X.

RF2T6W40X–Sezione istologica della palpebra umana (tarso) che mostra strati di tessuto che proteggono la cornea. Micrografia leggera colorata con ematossilina ed eosina.

RF2C85EET–Vista microscopica di fibre di cotone. Luce polarizzata, polarizzatori parzialmente incrociati.

RMTW1M8R–Immagine al microscopio di linee che si intersecano su un tampone di legali Quaderno, 25 maggio 2019. ()

RMKA1M5T–Cinconidina vetrino per microscopio fuso, cinconidina è un alcaloide trovato in China officinalis e Gongronema latifolium, polarizzata incrociata microfotografia.

RM2JKFT66–Le fotomicrografie del farmaco AZT sono state prese a 30x e 50x ingrandimenti. Per illuminare i cristalli, sono state usate tecniche di illuminazione polarizzate e a campo scuro. Si ritiene che AZT contribuisca a prevenire la replicazione dell'HIV, il virus dell'AIDS, noto anche come HTLV-III

RF2Y8MJ8G–Cristalli di metamizolo al microscopio. I cristalli vengono precipitati da una soluzione su un vetrino per microscopio e fotografati con luce polarizzata

RM2RTNC55–L'immagine presenta paracetamolo cristallizzato, fotografato attraverso il microscopio in luce polarizzata con un ingrandimento di 100X.

RFRTF5CX–Cristalli di conservante alimentare chiamato acido citrico, microscopio immagine fotografata in croce-luce polarizzata

RF2XPWK4F–Stelo Tilia, sezione trasversale, micrografo luminoso 8X. Stelo di basswood, noto anche come linden, sotto il microscopio leggero. Ematossilina-eosina colorata.

RF2J2C0T3–Immagine microscopica leggera che mostra il confronto istologico tra tessuto epatico umano sano e fegato affetto da steatosi epatica (steatosi epatica)

RMT19A6W–Campo scuro micrografia di luce di una gamba di afide, area raffigurato è di circa 243 micron ampia

RF2PC6HE2–Vista microscopica di SPUGE (Euphorbia sp.) bundle vascolare. Luce polarizzata con polarizzatori incrociati.

RMTW1MF6–Immagine al microscopio della struttura interna di una margherita (Gerbera Daisy) fiore a circa 30x di ingrandimento, 25 maggio 2019. ()

RMKA1M36–Cinconidina vetrino per microscopio fuso, cinconidina è un alcaloide trovato in China officinalis e Gongronema latifolium, polarizzata incrociata microfotografia.

RM2JKFTMT–Un'immagine di micrografia elettronica a scansione mostra un monostrato EPR polarizzato su un ponteggio biodegradabile. L'immagine viene accelerata per evidenziare l'impalcatura in blu, tre cellule RPE (marrone) e il processo apicale delle cellule monostrato RPE sono di colore verde chiaro.

RF2Y8MRG6–Cristalli di metamizolo al microscopio. I cristalli vengono precipitati da una soluzione su un vetrino per microscopio e fotografati con luce polarizzata

RM2RPEHAY–L'immagine presenta la larva di diptera, fotografata attraverso il microscopio in luce polarizzata con un ingrandimento di 100X.

RFRTF5BT–Cristalli di conservante alimentare chiamato acido citrico, microscopio immagine fotografata in croce-luce polarizzata

RF2R77C8W–Fibroide uterino. Micrografia di luce (LM) di una sezione attraverso il tessuto dall'utero, in un caso di fibroidi uterini (leiomiomi). Un fibroma è un benigni

RF2R7E8EE–Tendine, pezzo di sinuo, sezione, micrografia a 20X luci. Colorato con ematossilina ed eosina, al microscopio.